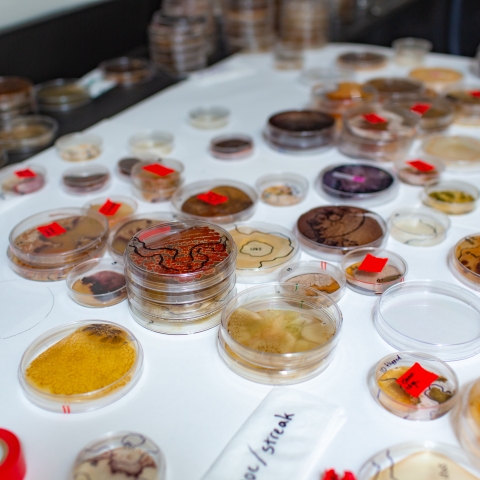
Lab table covered in petri dish samples.

Explore the Science of Life Through Research
All of our biology faculty maintain research programs in which students are active collaborators with many opportunities to participate in biological research. From microbial genetics to ecosystem dynamics, students explore new ideas and integrate biological knowledge while gaining experience with techniques in cutting-edge laboratory research.

Summer Research
The biology department also has a large and active summer research program, and offers free housing to participants. There are several mechanisms through which students can participate.

Research with Faculty
Faculty in the department also have individual research grants that fund summer research from institutions such as NIH, NSF and USDA.
Research Internships
Students participate in research both during the academic year and summer, working either at Trinity or at other universities or research institutions. Depending on the time of involvement and the nature of the project, students may have the chance to receive course credit and/or a stipend for their work.

Independent Study
Many students choose to participate in research during the semester, and while some choose to volunteer, most enroll in 1-3 hours of course credit (BIOL 3-90) for independent study.

McNair Scholars Program
The McNair Scholars Program provides graduate school preparation, including research support, for first-generation students and those from disadvantaged backgrounds.

Honors Research
Students in the Honors Program can participate in honors research. Honors research and the seminar are designed to provide the opportunity to do the bulk of the research associated with your honors thesis project.
Getting Started
Securing Undergraduate Research Opportunities
We hope that you'll find a position that will both challenge you and inspire you; however, it is important to understand that not all students who express an interest in a particular project will be able to work on that project.
Steps to securing a research opportunity Office of Experiential Learning